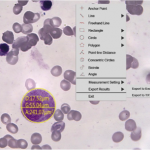

The Modus TEC-HDMI is a premium Ultra High Definition 8.3-megapixel optical measurement microscope. Produces ultra-sharp live pictures of your measurement objects up to 80x on 28" monitor at the same time providing a large field of view. Additionally, the Modus TEC4K-HDMI is a flexible system that can be configured with many different lenses, illumination, and stands to match the application.
Made for Ergonomic Use
Modus TEC-HDMI provides relief to the eyes, neck, and shoulders. The unique ergonomic design with a flexible working distance between 100mm- 150mm allows operators to sit comfortably in a good working posture and carry out their optical inspection tasks efficiently.
- Ultra-sharp images
- On-screen measurement
- Live image speed of 60 fps with 1920 x 1080 pixels
- Live image speed of 60 fps with 3840 x 2160 pixels
- Built-in 4K video recording
- Large field of view
- Selectable language: English, German, French
Files
| Attachment | Size |
|---|---|
| 524.13 KB |
The system can be configured with different optics, cameras, light sources, motorization and much more, contact us for more information.
Plug and play –HDMI interface for ease of installation on any HDMI monitor no need for a computer.